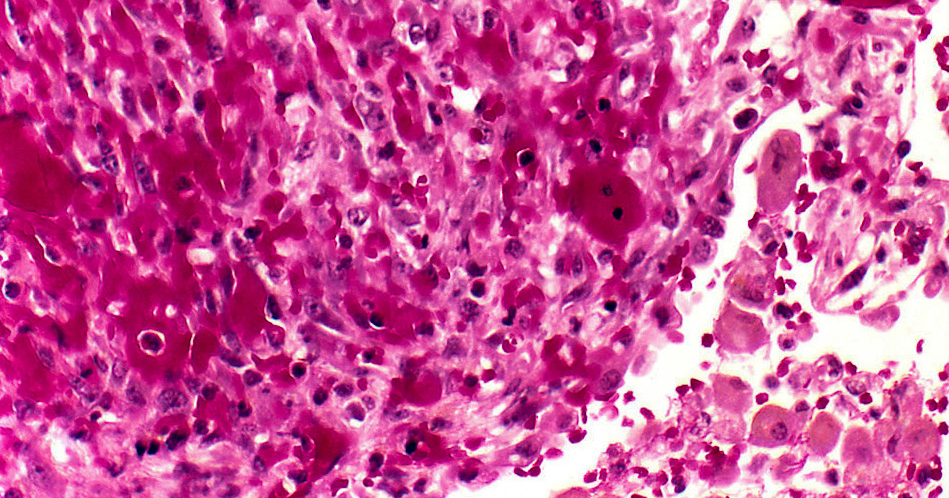

Спид Фото Кожи
Спортивные Костюмы Женские 2025 Год Фото
Картинки Про Иностранные Языки
Гремлин Добрый Фото
Поиск По Картинке Загрузить С Мобильного
Чай С Облепихой Красивое Фото
Найти Духи По Фото Онлайн
Татьяна Дмитриевна С Днем Рождения Картинки
Летящие Вороны Картинки
Кристина Кретова Фото
Пылесосы На Озон Цены И Фото Недорого
Поиск Местоположения По Фото
Картинки Живых Танков
Томаты Росе Фото
Спид Фото Кожи 114 фотографий